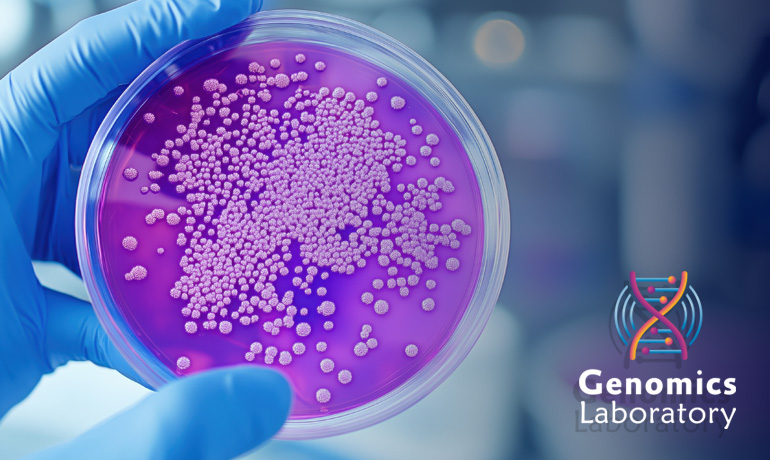
آزمایشگاه میکروبیولوژی

معرفی آزمایشگاه میکروبیولوژی
معرفی آزمایشگاه میکروبیولوژی
آزمایشگاه میکروبیولوژی به آزمایشگاه هایی گفته می شود که در آن ها به مطالعه و تجزیه و تحلیل میکروارگانیسم ها (میکروب ها) پرداخته می شود. میکروب ها شامل باکتری ها، ویروس ها، قارچ ها، جلبک ها و تک سلولی ها هستند که از نظر اندازه به حدی کوچک اند که قابل مشاهده با چشم غیر مسلح نیستند و برای مشاهده آن ها به میکروسکوپ نیاز است.
آزمایشگاه های میکروبیولوژی در حوزه های مختلفی از جمله پزشکی، محیط زیست، کشاورزی، صنعت و تحقیقاتی فعالیت می کنند. این آزمایشگاه ها در تشخیص بیماری ها، بهبود محصولات کشاورزی، کنترل آلودگی های محیطی و تولید محصولات بیوتکنولوژیک نقش بسیار مهمی دارند.
اهداف آزمایشگاه میکروبیولوژی
آزمایشگاه میکروبیولوژی با هدف بررسی و شناسایی میکروارگانیسم ها در محیط های مختلف و تجزیه و تحلیل رفتار آن ها در برابر شرایط مختلف طراحی شده است. مهم ترین اهداف این آزمایشگاه ها عبارتند از:
تشخیص بیماری های عفونی:
این آزمایشگاه ها در شناسایی و تشخیص بیماری های ناشی از میکروب ها مانند عفونت های باکتریایی، ویروسی، قارچی و انگلی بسیار مهم هستند.
پژوهش های علمی:
تحقیقات علمی در زمینه های مختلف میکروبیولوژی مانند ایمنی شناسی، ژنتیک میکروبی، مقاومت آنتی بیوتیکی و تکامل میکروب ها در این آزمایشگاه ها انجام می شود.
کنترل آلودگی:
آزمایشگاه های میکروبیولوژی می توانند آلودگی های محیطی مانند آب، خاک و هوا را مورد بررسی قرار دهند تا به شناسایی منابع آلودگی و کنترل آن ها پرداخته شود.
توسعه محصولات بیوتکنولوژیک:
میکروارگانیسم ها در تولید داروهای بیولوژیک، واکسن ها، آنزیم ها و مواد خوراکی نقش دارند و این آزمایشگاه ها به توسعه این محصولات کمک می کنند.
آزمایش های ایمنی شناسی و واکسن ها:
در این آزمایشگاه ها برای توسعه واکسن ها و تشخیص بیماری های ایمنی شناختی تست هایی انجام می شود.
تجهیزات آزمایشگاه میکروبیولوژی
آزمایشگاه میکروبیولوژی به منظور شناسایی، مطالعه و تجزیه وتحلیل میکروارگانیسم ها به تجهیزات ویژه ای نیاز دارد که برای انجام آزمایشات مختلف دقیق و ایمن طراحی شده اند. این تجهیزات به دسته های مختلف تقسیم می شوند، از جمله ابزارهای کشت، ابزارهای شناسایی، ابزارهای ایمنی و تجهیزات جانبی.
تجهیزات کشت میکروبی
این تجهیزات برای کشت، رشد و تفکیک میکروارگانیسم ها در محیط های کنترل شده استفاده می شوند:
انکوباتور (Incubator): دستگاهی برای تنظیم دما، رطوبت و گازهای موجود در هوا جهت رشد بهینه میکروارگانیسم ها. دمای معمول برای کشت باکتری ها حدود ۳۷ درجه سانتی گراد است.
آگار و محیط های کشت (Agar & Media): محیط های کشت مختلف برای رشد میکروارگانیسم ها، شامل آگارهای عمومی و اختصاصی که بستگی به نوع میکروارگانیسم دارند.
شرایط کشت (Culture Plates, Tubes): لوله های آزمایش، پلیت های کشت و ظروف دیگر برای کشت میکروارگانیسم ها.
آتونکلاو (Autoclave): دستگاهی که برای استریل کردن ابزارها و محیط های کشت استفاده می شود. دمای بالا و فشار در آن برای نابودی میکروارگانیسم ها به کار می رود.
لوپ میکروبی (Inoculating Loop): ابزاری برای انتقال و کشت میکروارگانیسم ها از نمونه های مایع یا جامد به محیط کشت.
تجهیزات شناسایی و آزمایش های بیوشیمیایی
برای شناسایی و تحلیل ویژگی های میکروارگانیسم ها از ابزار و دستگاه های تخصصی استفاده می شود:
میکروسکوپ نوری (Light Microscope): برای مشاهده ویژگی های میکروارگانیسم ها به صورت مستقیم. برای مشاهده ساختار میکروبی و رنگ آمیزی های مختلف به کار می رود.
میکروسکوپ الکترونی (Electron Microscope): برای مشاهده میکروارگانیسم ها با دقت بسیار بالا (مقیاس نانومتری) و بررسی ساختارهای داخلی سلولی.
پلیت های رنگ آمیزی (Staining Plates): برای رنگ آمیزی میکروارگانیسم ها جهت مشاهده ساختار آنها تحت میکروسکوپ، مانند رنگ آمیزی گرام.
کیفیت سنجی بیوشیمیایی (Biochemical Tests): برای شناسایی ویژگی های متابولیکی میکروارگانیسم ها. از جمله تست هایی مثل تست کاتالاز، تست کربوهیدرات ها و آزمایش های تخمیر.
دستگاه PCR (Polymerase Chain Reaction): برای شناسایی DNA میکروارگانیسم ها و تایید هویت گونه ها. این دستگاه معمولاً در آزمایشات مولکولی به کار می رود.
الکتروفورز (Gel Electrophoresis): برای جداسازی قطعات DNA و بررسی ویژگی های ژنتیکی میکروارگانیسم ها.
تجهیزات ایمنی و حفاظتی
به دلیل خطرات بالقوه ناشی از میکروارگانیسم ها، ایمنی در آزمایشگاه های میکروبیولوژی بسیار حائز اهمیت است. برخی تجهیزات ایمنی عبارتند از:
هود بیولوژیکی (Biological Safety Cabinet): یک محفظه ایمنی برای کار با نمونه های میکروبی خطرناک. این دستگاه با جریان هوا از انتشار آلودگی به محیط جلوگیری می کند.
دستکش ها و لباس های محافظ: برای جلوگیری از تماس مستقیم با مواد آلوده یا خطرناک.
ماسک ها و عینک ایمنی: برای جلوگیری از استنشاق ذرات میکروبی یا آسیب دیدن چشم ها هنگام کار با مواد شیمیایی.
فیلترهای HEPA (High-Efficiency Particulate Air): برای تصفیه هوا در داخل هودهای بیولوژیکی یا سیستم های تهویه.
آزمایشگاه های درجه ایمنی ۲ یا ۳ (BSL-2 or BSL-3 labs): محیط های آزمایشگاهی که دارای ایمنی بالاتر و تجهیزات کنترل آلودگی خاص برای کار با میکروارگانیسم های خطرناک تر هستند.
تجهیزات تحلیل و اندازه گیری
این تجهیزات برای تجزیه وتحلیل ویژگی های فیزیکی و شیمیایی میکروارگانیسم ها استفاده می شوند:
اسپکتروفتومتر (Spectrophotometer): برای اندازه گیری جذب نور توسط میکروارگانیسم ها یا محیط های کشت.
کروماتوگرافی (Chromatography): برای جداسازی و تحلیل ترکیبات شیمیایی تولیدشده توسط میکروارگانیسم ها.
دستگاه pH متر: برای اندازه گیری pH محیط کشت و بررسی اثرات آن بر رشد میکروارگانیسم ها.
تجهیزات کشت و نگهداری در دماهای پایین
فریزر و یخچال آزمایشگاهی: برای نگهداری نمونه ها، محیط های کشت یا میکروارگانیسم های زنده در دماهای پایین.
دستگاه فریزدرایر (Lyophilizer): برای خشک کردن میکروارگانیسم ها و نگهداری آن ها به طور طولانی مدت در حالت منجمد.
تجهیزات شستشو و استریل
دستگاه شستشوی اتوماتیک (Automatic Washer): برای شستشوی ابزار و ظروف آزمایشگاهی.
دستگاه استریل کننده (Sterilizer): برای استریل کردن ظروف و ابزارهای آزمایشگاهی قبل و بعد از استفاده.
کاربردهای آزمایشگاه میکروبیولوژی
آزمایشگاه های میکروبیولوژی نقشی اساسی در پیشرفت های علمی و بهداشتی ایفا می کنند. این آزمایشگاه ها به دلیل توانایی شناسایی، مطالعه، و تجزیه وتحلیل میکروارگانیسم ها (باکتری ها، قارچ ها، ویروس ها، پروتوزوئرها، و دیگر میکروب ها)، در بسیاری از زمینه های علمی، صنعتی، پزشکی، و محیط زیست استفاده می شوند. در ادامه به مهم ترین کاربردهای آزمایشگاه میکروبیولوژی پرداخته می شود.
ناسایی و تشخیص بیماری های عفونی
آزمایشگاه های میکروبیولوژی برای شناسایی عاملین بیماری های عفونی (مانند باکتری ها، ویروس ها، قارچ ها و پروتوزوئرها) کاربرد دارند.
تشخیص بیماری های باکتریایی:
آزمایشگاه ها از کشت میکروبی، آزمون های بیوشیمیایی، PCR، و رنگ آمیزی های خاص برای شناسایی باکتری ها و ارگانیسم های عامل بیماری استفاده می کنند.
تشخیص بیماری های ویروسی:
آزمایشگاه های میکروبیولوژی برای شناسایی ویروس ها از روش هایی مانند PCR، ELISA، و کشت سلولی استفاده می کنند.
بیماری های قارچی و تک سلولی:
آزمایشگاه ها برای شناسایی انواع قارچ ها و پروتوزوئرها، از کشت های اختصاصی، میکروسکوپ فلورسانس، و تست های بیوشیمیایی استفاده می کنند.
بررسی حساسیت به آنتی بیوتیک ها (Antibiotic Sensitivity Testing)
آزمایشگاه های میکروبیولوژی برای تعیین مقاومت میکروب ها به داروهای ضدباکتریایی (آنتی بیوتیک ها) از روش هایی مانند آزمون دیسک دیفیوزیون (Kirby-Bauer)، MIC (Minimum Inhibitory Concentration) و آزمایش های مولکولی استفاده می کنند. این اطلاعات برای تجویز داروهای مؤثرتر و کنترل بیماری های عفونی حائز اهمیت است.
آزمایش های مقاومتی:
این آزمایش ها به شناسایی سویه های مقاوم به آنتی بیوتیک ها و جلوگیری از مقاومت میکروبی کمک می کنند.
تشخیص بیماری های مولد مقاومت:
شناسایی بیماری هایی که توسط باکتری های مقاوم به درمان ایجاد می شوند، از اهمیت بالایی برخوردار است.
تحقیقات پزشکی و بیوتکنولوژی
آزمایشگاه های میکروبیولوژی برای انجام تحقیقات پزشکی و علمی، از جمله تحقیق در مورد بیماری های جدید، ویژگی های میکروب ها، و آزمایش های دارویی، به کار می روند.
توسعه واکسن ها:
آزمایشگاه های میکروبیولوژی برای تحقیق و تولید واکسن ها از جمله واکسن های ضدباکتریایی، ضدویروسی، و ضدقارچی استفاده می کنند.
مطالعه ژنتیک میکروبی:
برای تجزیه وتحلیل ویژگی های ژنتیکی میکروب ها، از تکنیک های پیشرفته مانند PCR، توالی یابی DNA، و الکتروفورز استفاده می شود. این تحقیقات به درک بهتر بیماری ها و میکروب ها کمک می کند.
شناسایی و کنترل آلودگی در صنایع مختلف
آزمایشگاه های میکروبیولوژی در شناسایی و کنترل آلودگی های میکروبی در صنایع مختلف کاربرد دارند.
صنایع غذایی و نوشیدنی:
آزمایشگاه های میکروبیولوژی برای شناسایی آلودگی های میکروبی در محصولات غذایی، نوشیدنی ها، و مواد اولیه از جمله باکتری های بیماری زا (مثل Salmonella و E. coli) استفاده می کنند. این اطلاعات برای اطمینان از ایمنی غذایی حیاتی است.
صنعت داروسازی:
در تولید داروهای بیولوژیک و واکسن ها، آزمایشگاه های میکروبیولوژی برای شناسایی و جلوگیری از آلودگی میکروبی استفاده می شوند.
آب و فاضلاب:
آزمایشگاه های میکروبیولوژی برای شناسایی آلودگی های میکروبی در منابع آب، فاضلاب، و سایر منابع آبی به ویژه برای اطمینان از سلامت عمومی کاربرد دارند.
بررسی محیط زیست و اکولوژی میکروبی
میکروب ها نقش مهمی در اکوسیستم ها ایفا می کنند. آزمایشگاه های میکروبیولوژی برای مطالعه روابط میکروب ها با محیط زیست، از جمله خاک، آب، و هوا، استفاده می شوند.
مطالعه آلودگی محیطی:
میکروب ها می توانند عامل آلودگی های محیطی مانند نفت، فلزات سنگین و مواد شیمیایی باشند. آزمایشگاه ها از روش های میکروبی برای بررسی و کاهش این آلودگی ها استفاده می کنند.
بیوتکنولوژی محیطی (Bioremediation):
در این روش، از میکروب ها برای تجزیه و کاهش آلودگی های شیمیایی و زیستی استفاده می شود. آزمایشگاه ها برای بررسی کارایی میکروب ها در پاکسازی محیط به ویژه در موارد آلودگی های نفتی و مواد سمی به کار می روند.
کاربرد در تشخیص بیماری های انسان و دام
آزمایشگاه های میکروبیولوژی در تشخیص و درمان بیماری های انسانی و دام پزشکی نقش حیاتی دارند.
تشخیص بیماری های مشترک بین انسان و دام (Zoonotic diseases):
بیماری هایی که از حیوانات به انسان منتقل می شوند، مانند سل، بیماری های روده ای و هاری، توسط آزمایشگاه های میکروبیولوژی شناسایی می شوند.
تست های تشخیصی دامپزشکی:
شناسایی و درمان بیماری های میکروبی در دام ها مانند عفونت های تنفسی، گوارشی، و پوستی با استفاده از آزمایش های میکروبیولوژیک انجام می شود.
تجزیه وتحلیل DNA و RNA میکروبی
آزمایشگاه های میکروبیولوژی از تکنیک های مولکولی برای مطالعه ویژگی های ژنتیکی میکروب ها و ردیابی تغییرات ژنتیکی استفاده می کنند.
شناسایی ژن های خاص:
با استفاده از تکنیک هایی مانند PCR، می توان ژن های خاص میکروب ها را شناسایی و ردیابی کرد. این تکنیک ها برای شناسایی سویه های خاص و بررسی ویژگی های ژنتیکی آن ها ضروری هستند.
مطالعه گونه های جدید میکروبی:
با استفاده از توالی یابی DNA و RNA، می توان گونه های جدید میکروبی را شناسایی کرد و حتی درک بهتری از روند تکامل و تنوع میکروب ها به دست آورد.
تست های آلرژی و حساسیت
در برخی آزمایشگاه های میکروبیولوژی، تست های حساسیت به مواد آلرژی زا که می توانند از میکروب ها یا ترکیبات آن ها به وجود آیند، انجام می شود.
آزمایش های حساسیت به قارچ ها:
آزمایشگاه ها می توانند برای شناسایی و تشخیص حساسیت به انواع قارچ ها که عامل بیماری های تنفسی هستند، مانند قارچ های آسپرژیلوس و کاندیدا، استفاده شوند.
تحقیقات در بیو تکنولوژی و تولید دارو
آزمایشگاه های میکروبیولوژی در تولید داروهای بیولوژیک، آنزیم ها، و مواد دارویی جدید نیز کاربرد دارند.
تولید آنتی بیوتیک ها:
بسیاری از داروهای ضدباکتریایی مانند پنی سیلین و تتراسایکلین از میکروب ها تولید می شوند. آزمایشگاه ها به تولید و بهینه سازی این داروها کمک می کنند.
تولید پروتئین های درمانی:
میکروب ها به ویژه باکتری ها و مخمرها برای تولید پروتئین های درمانی مانند انسولین انسانی و هورمون های رشد استفاده می شوند.
مواد مصرفی عمومی و تخصصی در آزمایشگاه میکروبیولوژی
در آزمایشگاه های میکروبیولوژی، برای انجام تحقیقات و آزمایش های میکروبی از مواد مصرفی مختلفی استفاده می شود. این مواد می توانند به دو دسته عمومی و تخصصی تقسیم شوند. مواد عمومی بیشتر برای کارهای روزمره و ساده استفاده می شوند، در حالی که مواد تخصصی برای انجام آزمایش های پیچیده تر و دقیق تر به کار می روند.
مواد مصرفی عمومی
محیط های کشت (Culture Media)
آگارهای عمومی (General Purpose Agar):
مانند نوتریک آگار، آگار TSA که برای کشت و رشد عمومی میکروب ها به کار می روند.
آگارهای انتخابی (Selective Agar):
محیط هایی که برای انتخاب یا تشخیص میکروب های خاص از دیگر میکروب ها طراحی شده اند، مثل آگار MacConkey برای شناسایی باکتری های گرام منفی.
آگارهای دیفرانسیلی (Differential Agar):
مانند آگار EMB یا آگار Blood که علاوه بر انتخاب میکروب های خاص، ویژگی های خاص مانند همولیز یا عدم همولیز را نیز نشان می دهند.
ظروف کشت و شیشه آلات
پتری دیش (Petri Dishes):
برای کشت و مشاهده رشد میکروب ها.
رک های آزمایشگاهی (Test Tubes):
برای کشت های مایع و آزمایش های مختلف میکروبی.
پیپت ها (Pipettes):
برای اندازه گیری دقیق حجم مایعات و محیط های کشت.
فلاسک های آزمایشگاهی (Flasks):
برای کشت های بزرگ تر و شرایط محیطی خاص.
مواد شیمیایی عمومی
آب مقطر و محلول های بافر (Buffer Solutions):
برای آماده سازی محیط های کشت و محافظت از pH محیط کشت.
اتانول و ضدعفونی کننده ها:
برای استریل کردن محیط ها، ابزارها و ظروف آزمایشگاهی.
آب و محلول های نمک دار:
برای شستن نمونه ها و محیط های کشت.
میکروسکوپ ها و لوازم مشاهده
لام های شیشه ای (Glass Slides):
برای مشاهده میکروب ها تحت میکروسکوپ.
پوشش های میکروسکوپی (Coverslips):
برای پوشاندن نمونه ها و جلوگیری از آلودگی و تبخیر.
رنگ ها و رنگ آمیزی ها (Staining Dyes):
مانند کریستال ویولت و یودین برای رنگ آمیزی نمونه ها و تسهیل مشاهده میکروب ها تحت میکروسکوپ.
مواد مصرفی تخصصی
محیط های کشت تخصصی (Specialized Media)
محیط های انتخابی برای باکتری های خاص:
مانند آگار Sabouraud برای قارچ ها یا آگار Cetrimide برای باکتری seudomonas.
محیط های کشت مولکولی:
برای کشت و تکثیر ویروس ها و برخی از باکتری های خاص از محیط های کشت تخصصی مانند Medium 199 استفاده می شود.
محلول های شیمیایی خاص
محلول های آنتی بیوتیکی:
برای بررسی حساسیت باکتری ها به آنتی بیوتیک ها از محلول های خاص با آنتی بیوتیک های مختلف استفاده می شود.
مواد شیمیایی حساس به نور یا گرما:
مانند آگار های خاص برای تثبیت pH یا محلول های مواد شیمیایی حساس به دما که باید در دماهای خاصی نگهداری شوند.
دستگاه ها و مواد تشخیصی
کیت های PCR و توالی یابی DNA:
برای شناسایی ژن ها و تعیین توالی DNA و RNA در میکروب ها و بررسی تنوع ژنتیکی میکروارگانیسم ها.
کیت های ELISA (Enzyme-Linked Immunosorbent Assay):
برای شناسایی آنتی ژن ها یا آنتی بادی های خاص در نمونه ها.
کیت های حساسیت آنتی بیوتیکی (Antibiotic Sensitivity Kits)
کیت های Kirby-Bauer Disk Diffusion:
برای آزمایش حساسیت باکتری ها به آنتی بیوتیک ها، که معمولاً شامل دیسک های آنتی بیوتیکی و محیط های کشت است.
مواد مورد نیاز برای کشت ویروس ها
محیط های کشت سلولی:
برای رشد ویروس ها از محیط های کشت سلولی مانند RPMI یا DMEM استفاده می شود.
آنتی بادی های اختصاصی:
برای شناسایی ویروس ها و آنتی ژن های خاص در نمونه های کشت شده.
مواد استفاده شده در تحقیقات ژنتیک و پروتئومیک
رایج ترین مواد مصرفی برای تجزیه وتحلیل پروتئین ها:
مانند سابسترا های مخصوص آنزیم ها و کیت های تعیین توالی پروتئین.
کیت های DNA/RNA Extraction:
برای استخراج DNA و RNA از میکروب ها برای استفاده در آزمایش های مولکولی و ژنتیکی.
اهمیت یادگیری مفاهیم آزمایشگاه میکروبیولوژی برای اشتغال
یادگیری مفاهیم پایه و تخصصی در آزمایشگاه های میکروبیولوژی نه تنها به عنوان ابزاری برای انجام آزمایش های علمی و تحقیقاتی، بلکه به عنوان عامل کلیدی در موفقیت شغلی و اشتغال در این حوزه نیز اهمیت دارد. در اینجا به بررسی دلایل اهمیت یادگیری مفاهیم در این رشته پرداخته می شود.
رشد فرصت های شغلی در بخش های مختلف
آزمایشگاه های میکروبیولوژی در بخش های مختلف صنعتی، پزشکی، کشاورزی و محیط زیست به طور مداوم در حال گسترش هستند. در نتیجه، فارغ التحصیلان و افراد متخصص با آگاهی از مفاهیم پایه و پیشرفته میکروبیولوژی، می توانند وارد این بازار کار پررونق شوند.
صنایع داروسازی و بیوتکنولوژی:
در این صنایع، مهارت های میکروبیولوژیک برای تولید داروهای بیولوژیک، واکسن ها و آنتی بیوتیک ها بسیار ضروری است.
صنایع غذایی و کشاورزی:
در این بخش ها برای بررسی کیفیت و سلامت محصولات غذایی و مبارزه با آلودگی های میکروبی، نیاز به متخصصین با مهارت های میکروبیولوژیک وجود دارد.
آزمایشگاه های پزشکی:
تشخیص بیماری های عفونی و بررسی حساسیت میکروب ها به درمان نیازمند دانش تخصصی در میکروبیولوژی است. همچنین در تحقیقات بیماری ها، توسعه واکسن ها و داروها، افراد با دانش میکروبیولوژی جایگاه مهمی دارند.
توانمندی در حل مشکلات و نوآوری در تحقیقات علمی
یادگیری مفاهیم علمی و عملی در آزمایشگاه میکروبیولوژی به شما کمک می کند تا بتوانید در حل مسائل پیچیده و نوآوری در تحقیقات و فرآیندهای علمی گام بردارید. این مهارت ها به ویژه در موارد زیر اهمیت دارند:
توسعه تکنیک ها و روش های جدید:
دانش در مورد روش های جدید مانند PCR، ELISA، Next-Generation Sequencing و سایر تکنیک های مولکولی می تواند شما را قادر سازد تا راهکارهای جدید برای حل مشکلات میکروبیولوژیکی ارائه دهید.
تحقیقات بیماری های نوظهور:
توانایی شناسایی و مقابله با بیماری های نوظهور مانند ویروس ها و باکتری های مقاوم به آنتی بیوتیک، از جمله مواردی است که افراد متخصص در این رشته می توانند در آن نقش ایفا کنند.
تطبیق با فناوری های نوین و ابزارهای پیشرفته
در دنیای امروز، تجهیزات و ابزارهای آزمایشگاهی به طور مداوم در حال تغییر و پیشرفت هستند. یادگیری مفاهیم میکروبیولوژی به شما کمک می کند که با فناوری های نوین و ابزارهای پیشرفته آشنا شوید و توانایی استفاده بهینه از آن ها را پیدا کنید.
استفاده از دستگاه ها و ابزارهای پیشرفته:
ابزارهایی مثل میکروسکوپ های فلورسانس، سانتریفیوژهای سرعت بالا، سیستم های PCR و کیت های آنالیز ژنتیکی نیازمند آگاهی دقیق از نحوه عملکرد و کاربرد صحیح هستند. این دانش می تواند به شما کمک کند تا در کار با این تجهیزات به دقت و کارآمدی بالا دست یابید.
آگاهی از نرم افزارها و پایگاه های داده:
برای تجزیه و تحلیل داده ها و اطلاعات آزمایشگاهی، آشنایی با نرم افزارهای آماری و زیستی مانند SPSS، Bioinformatics Tools، و LIMS (سیستم های مدیریت اطلاعات آزمایشگاهی) می تواند شما را برای تحلیل داده ها و گزارش دهی دقیق تر آماده کند.
رشد شغلی و پیشرفت در مسیرهای تخصصی
افرادی که مفاهیم میکروبیولوژی را به خوبی یاد می گیرند و درک عمیقی از این رشته پیدا می کنند، می توانند در مسیرهای شغلی تخصصی پیشرفت کنند. در اینجا به چند مسیر شغلی اشاره می کنیم:
متخصص آزمایشگاه میکروبیولوژی:
در بسیاری از مراکز درمانی و آزمایشگاه ها، نیاز به متخصصینی است که توانایی انجام انواع آزمایش ها و تشخیص بیماری های میکروبی را داشته باشند.
بیوتکنولوژیست ها:
افرادی که در زمینه تولید دارو، واکسن و سایر محصولات بیوتکنولوژیک فعالیت می کنند، نیاز به دانش میکروبیولوژیک دارند.
پژوهشگر علمی و دانشگاهی:
کسانی که به عنوان محقق در زمینه های مختلف میکروبیولوژی، از جمله پزشکی، محیط زیست، و کشاورزی فعالیت می کنند، به درک عمیق از مفاهیم میکروبیولوژی نیاز دارند.
متخصص کنترل کیفیت:
در صنایع غذایی، دارویی و پزشکی، افراد با مهارت های میکروبیولوژی در کنترل کیفیت محصولات نقش مهمی دارند.
اهمیت در برخورد با مشکلات بهداشتی و بحران های سلامت
یادگیری مفاهیم میکروبیولوژی به ویژه در مواقع بحران های بهداشتی مانند شیوع بیماری های عفونی و پاندمی ها از اهمیت ویژه ای برخوردار است. دانش میکروبیولوژی می تواند به شما کمک کند که در زمینه های زیر موثر باشید:
مقابله با بیماری های عفونی:
در هنگام شیوع بیماری ها، به ویژه بیماری های ویروسی یا باکتریایی، دانش میکروبیولوژی به شما امکان می دهد که بتوانید در آزمایشگاه های تشخیصی و پزشکی به سرعت تشخیص های دقیق بدهید.
پاسخ به بحران های بهداشتی:
در مواقع بحران مانند شیوع ویروس کرونا، فرد متخصص میکروبیولوژی می تواند در تحقیقات، شناسایی ویروس ها و تولید واکسن ها نقش کلیدی ایفا کند.
توسعه مهارت های ارتباطی و همکاری تیمی
در بسیاری از محیط های علمی و تحقیقاتی، یادگیری مفاهیم میکروبیولوژی به شما کمک می کند تا در محیط های تیمی فعالیت کنید و با دیگر متخصصین همکاری نمایید. این مهارت ها عبارتند از:
نوشتن گزارش های علمی و تحقیقاتی:
توانایی نوشتن و تحلیل دقیق گزارش های آزمایشگاهی و تحقیقاتی در زمینه میکروبیولوژی یک مهارت کلیدی در اشتغال است.
ارتباط مؤثر با همکاران:
متخصصین میکروبیولوژی باید توانایی برقراری ارتباط مؤثر با همکاران خود از جمله پزشکان، پژوهشگران، و تکنسین ها را داشته باشند.